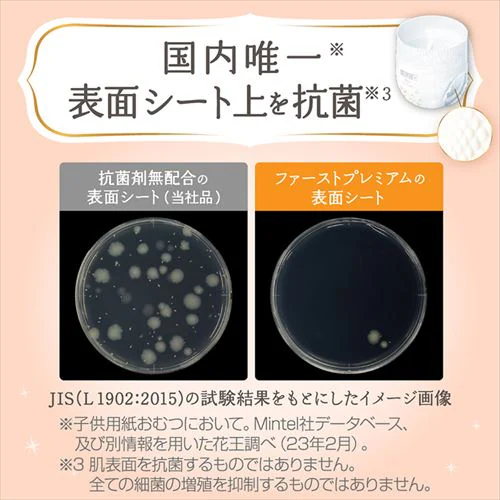
�y48���z�����[�Y �t�@�[�X�g�v���~�A�� �e�[�v M�T�C�Y 48�����y�v���U�}�[�P�b�g�z_8

獲得予定ポイント
- 通常ポイント内訳
- お買い物ポイント
- 1倍
- 合計
- 18ポイント
※ポイントの獲得には会員ログインが必要です
獲得予定ポイント
- 通常ポイント内訳
- お買い物ポイント
- 1倍
- 合計
- 73ポイント
※ポイントの獲得には会員ログインが必要です
獲得予定ポイント
- 通常ポイント内訳
- お買い物ポイント
- 1倍
- 合計
- 18ポイント
※ポイントの獲得には会員ログインが必要です
- HOME
- イベント
- 日用品
- べビサポ会員対象ページ
- べビサポ会員【ベビー】対象商品
- 【48枚】メリーズ ファーストプレミアム テープ Mサイズ 48枚入
商品をシェアする
4.83 12件
【48枚】メリーズ ファーストプレミアム テープ Mサイズ 48枚入
リンクをコピーしました。
【48枚】メリーズ ファーストプレミアム テープ Mサイズ 48枚入
1〜3日以内発送
- ¥1,830(税込)
- 18ポイント
- (1倍)
サイズ:選択してください
セット数:選択してください
【ラクラク定期便価格設定について】
お届け4日前の商品価格から割引した価格でお届けします。セール時の売価でご購入いただきますと2回目以降価格変更となる可能性がございます。予めご了承ください。
肌研究生まれで、はじめての肌に上質な厳選素材を。
独自のふんわりエアinクッションが肌あたりやわらか、うんちも肌につきにくい。
肌に触れる面には天然植物成分アルガンオイル配合。
交換時が一目でわかる「おしっこサイン」つき
※リニューアルに伴い、お届け時期によってパッケージが異なる場合がございます。予めご了承くださいませ。
お届け4日前の商品価格から割引した価格でお届けします。セール時の売価でご購入いただきますと2回目以降価格変更となる可能性がございます。予めご了承ください。
肌研究生まれで、はじめての肌に上質な厳選素材を。
独自のふんわりエアinクッションが肌あたりやわらか、うんちも肌につきにくい。
肌に触れる面には天然植物成分アルガンオイル配合。
交換時が一目でわかる「おしっこサイン」つき
※リニューアルに伴い、お届け時期によってパッケージが異なる場合がございます。予めご了承くださいませ。
もっと見る
※製品は予告なく仕様を変更する場合がございます。あらかじめご了承ください。
●内容量/体重目安
新生児サイズ:66枚(〜5kgまで)
Sサイズ:60枚(4〜8kgまで)
Mサイズ:48枚(6〜11kgまで)
●材質
表面材:ポリエステル/ポリオレフィン不織布
吸水材:吸収紙/綿状パルプ/アクリル系高分子吸水材
防水材:ポリオレフィン系フィルム
止着材:ポリオレフィンなど
伸縮材:ポリウレタン
結合材:スチレン系エラストマー合成樹脂など
●タイプ:テープ
| JAN |
4901301388032 [M|4個セット]
|
|---|
※当商品はお取り寄せ品の為、在庫の確認及び商品のお届けまでお時間を頂く場合がございます。
また、商品がメーカーにて完売となっていた場合、キャンセル又は注文内容の変更をお願いいたしております。
予めご了承くださいますようお願いいたします。 ■こちらの商品はアイリスプラザがセレクトしたオススメ商品です。
また、商品がメーカーにて完売となっていた場合、キャンセル又は注文内容の変更をお願いいたしております。
予めご了承くださいますようお願いいたします。 ■こちらの商品はアイリスプラザがセレクトしたオススメ商品です。
商品情報

グーンシリーズ


パンパースシリーズ







メリーズシリーズ





ゲンキシリーズ








※完売により、ご注文後にお断りする場合がございます。ご了承ください。